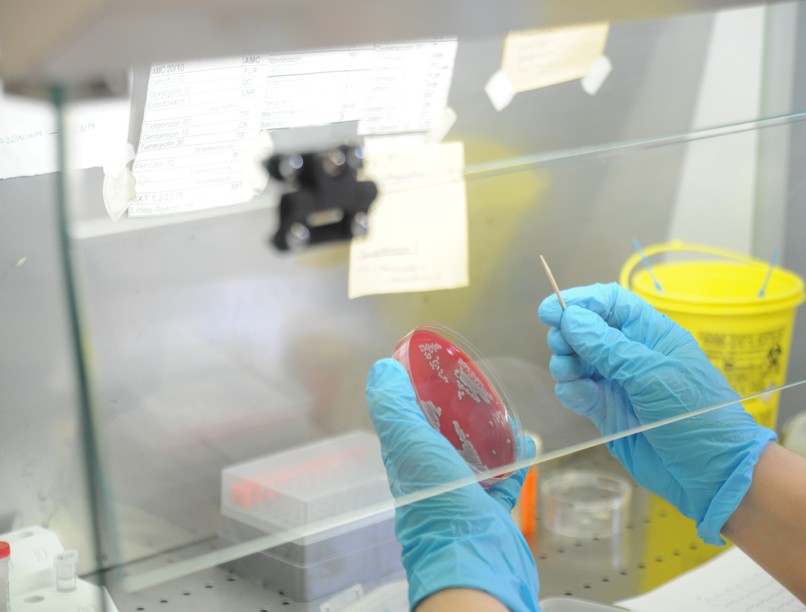
multirezisztens baktériumok, antibiotikum, rezisztencia, MRSA, fertőzés

2050-re a multirezisztens baktériumok okozta megbetegedések vezető halálokká válhatnak.
Ahogyan az ember esetében, úgy az állatoknál sem mindegy, hogy mikor, milyen betegségre kaphatnak antibiotikumot. Reményt keltő három Európai Uniós ügynökség közös jelentése, mely bemutatja az antibiotikum-fogyasztás és az antibiotikum-rezisztencia alakulását Európában. E szerint a legtöbb EU-országban kisebb-nagyobb mértékben csökken az antibiotikumok alkalmazása, némelyekben az élelmiszertermelő állatok esetében alacsonyabb, mint az embereknél. Magyarországon sajnos a csökkenés inkább kisebb mértékű és gazdasági haszonállatok tekintetében, egységnyi állati termékre vetítve az EU-ban az ötödik legnagyobb mennyiségű antibiotikum felhasználó ország vagyunk. Tehát van tennivalónk.
Az Európai Élelmiszerbiztonsági Hatóság (EFSA), az Európai Gyógyszerügynökség (EMA) és az Európai Betegségmegelőzési és Járványvédelmi Központ (ECDC) tavaly nyári közleménye szerint a csökkenő antibiotikumok alkalmazása azt sugallja, hogy a nemzeti szinten hozott intézkedések hatékonyak. A kolisztint is magában foglaló polimixinek nevű antibiotikum-csoport használata EU átlagban majdnem a felére csökkent 2016 és 2018 között. Ez pozitív fejlemény, mivel a kolisztint kórházakban is alkalmazzák egyes multirezisztens baktériumokkal fertőzött betegek kezelésére. Itt is meg kell jegyeznünk azonban, hogy hazánkban korántsem ilyen mértékű a csökkenés.
Az antibiotikum rezisztencia egyre növekvő kockázat emberekre és állatokra egyaránt
„A multirezisztens, azt jelenti, hogy olyan feltételes kórokozó baktériumok (pl. meticillin rezisztens Staphylococcus aureus, közkeletű nevén MRSA, amely az összes penicillin és cefalosporin csoportba tartozó antibiotikumra ellenálló) fognak elszaporodni (kiválasztódni az antibiotikumokra érzékeny baktérium populációból) melyek ellen nagyon nehéz, vagy lehetetlen hatékony kezelést végezni. Minden élőlénynek - így a baktériumoknak is – célja a túlélés és szaporodás. Minél több antibiotikumot használ az emberiség, annál több kerül ki a környezetbe aktív hatóanyagként, elpusztítva az arra érzékeny baktériumokat és túlélési előnyt biztosítva az ellenállóknak (rezisztenseknek). A rezisztencia természetes genetikai módosulás következménye, amely átmegy az utód generációkba, de ami még ennél is fontosabb, gyakran a sejtmagon kívüli génállományhoz (ún. „plazmidokhoz”) kötött, amelyet akár eltérő fajba tartozó, vagy egymással egyáltalán nem rokon baktériumok is átadhatnak egymásnak, biztosítva ezzel a rezisztencia gyors és hatékony terjedését.
Tisztában kell lennünk azzal, hogy az összetettebb szervezetekben (ember, háziállatok) élő óriási baktérium populáció részben önálló, behatárolt egységeket alkot (vagyis az embernek, a sertésnek, a kutyának, a tyúknak megvan a saját fajára jellemző baktérium készlete), de részben össze is függenek egymással, elsősorban a környezetünkben élő baktérium populáció közvetítésével.
Az antibiotikum helyes szedése: ezeket tartsa be - olvasson tovább!
Tehát a rezisztenciáért felelős gének tárháza és kicserélődési terjedési terepe a környezet is
Más szóval nemcsak abban az emberben vagy állatban vagy növényben alakulnak ki rezisztens baktériumok, amelyeket konkrétan antibiotikumokkal kezelnek, hanem a környezetben is. Ezért veszélyesek a környezetbe kikerülő antibiotikum hatóanyagok. A baj akkor tetőződik, ha bármely okból legyengült védekezőképességű emberi (vagy állati) szervezetben a multirezisztens feltételes kórokozó baktérium elszaporodik és betegséget okoz.
Legyengült immunrendszer sokmindentől lehet:
- fertőző betegség (pl. influenza, covid),
- daganatos betegségek,
- transzplantáció,
- egyes gyógyszerek (pl. szteroidok) tartós alkalmazása.
Ilyen esetekben a multirezisztens baktérium által okozott betegséget nem lehet antibiotikumokkal meggyógyítani a rezisztencia miatt és végül a beteg meghal. Mindez oda vezethet, hogy 2050-re a multirezisztens baktériumok okozta bármilyen betegség lehet a vezető halálok, az egész világban. Végső soron az ember, az állat és a környezet egészsége egy – ezt mondja ki helyesen a „One Health” kezdeményezés, amelynek egyik célja 2030-ra az antibiotikum felhasználás felére csökkentése” – mondta Branduse László, a VetControll ügyvezetője.
Mire adható antibiotikum?
A vírusokra nem hatnak az antibiotikumok, vírusfertőzés esetén legfeljebb abban az esetben indokolt a használatuk, ha szinte biztosra vehető, hogy van bakteriális felülfertőződés is. Csakis a bakteriális eredetű fertőző betegségek gyógykezelésére adható antibiotikum. A megelőző kezelés csak nagyon ritka esetekben indokolt, pl. egy nagyobb operáció előtt.
„Még 100 év sem telt el a penicilin felfedezése óta, ebből látszódik mennyire gyorsan változik az orvostudomány is. Az állatgyógyászattal párhuzamosan a humán gyógyászatban is egyre inkább az lesz a „trend”, hogy nem adnak azonnal antibiotikumot. Nagyon fontos, és nem győzzük elégszer hangsúlyozni, hogy csak akkor kell szedni az antibiotikumot, ha nagyon szükséges. Állategészségügyi Diagnosztikai Laboratóriumként mi beálltunk azon rendelet mögé, hogy biztosított legyen laborháttér, és minél több vizsgálat megvalósuljon annak érdekében, hogy tudatos és célzott antibiotikum használatról beszéljünk. Célzott alatt értjük, hogy a megbetegedést okozó baktérium ellen nagyon hatékony, de lehetőleg nem túl széles hatásspektrumú készítményt használjunk. A sörétes puska nem engedélyezett a céllövöldében” – tette hozzá Branduse László.
Antibiotikum nem csak a szervezetben, hanem a környezetünkben is
„A folyamatot úgy kell elképzelni, hogy az elhullott állatból, a diagnosztikai labor minden esetben kitenyészti a kórokozót. Erre a kórokozóra egy antibiotikum rezisztencia eredményt fog adni, más szóval: mely antibiotikumokat milyen adagban, mennyi időtartamban a legcélszerűbb használni, ahhoz, hogy a legkevesebb antibiotikum felhasználásával a többi állatnál eredményes legyen a gyógyulás. Sok esetben olyan mennyiségben adják az antibiotikumot, hogy nem is szükséges akkora dózis az adott állatállománynak, sőt tovább megyek, lehet, hogy egyáltalán nem is kell antibiotikumot adni.
"A túlzott mennyiség viszont kárt okoz, bekerül a szennyvízbe, a kiszórt szerves trágyába, ezáltal bejut a környezetünkbe is. Az EU-s rendelet éppen ezt akadályozza meg, azzal, hogy megelőzés céljából nem adható antibiotikum” – hívta fel a figyelmet a VetControll ügyvezetője, aki szerint az állattartók között egyre nagyobb törekvés van erre.
Az állattenyésztésben, állategészségügyben régóta szigorúan szabályozott, hogy csak antibiotikum mentes állati terméket (hús, tej, tojás) lehet emberi fogyasztásra forgalomba hozni. Ezt célozza az élelmezés egészségügyi várakozási idő, ami minden antibiotikum készítményre megszabja, hogy utolsó alkalmazása után mennyi ideig nem kerülhet emberi fogyasztásra az állati termék. Ennek betartását az élelmiszerek maradékanyag vizsgálatával szigorúan ellenőrzik, ezért a valós, jelentős veszélyt az emberre nézve – a közhiedelemmel ellentétben – nem az antibiotikumokat tartalmazó állati termékek fogyasztása jelenti, hanem egyrészt az embergyógyászatban fennálló nem eléggé megalapozott és körültekintő antibiotikum használat, másrészt a fentebb elmondott környezeti antibiotikum szennyezés és ennek nyomán terjedő rezisztencia.
Nagyon fontos, hogy az emberek (mint gyógyszer- illetve állati termék fogyasztók, valamint társállat tartók) szemét felnyissuk, figyelmét felhívjuk a körültekintő, megfontolt antibiotikum használatra: ne adjunk sem embernek, sem haszonállatnak, de még társállatnak se antibiotikumot anélkül, hogy ne végeztettünk volna mikrobiológiai vizsgálatot. Ez egy új irány, de ez az egyetlen járható út a hosszantartó egészségért” – mondta Branduse László.
Kövesse az Egészségkalauz cikkeit a Google Hírek-ben, a Facebook-on, az Instagramon vagy a X-en,Tiktok-on is!